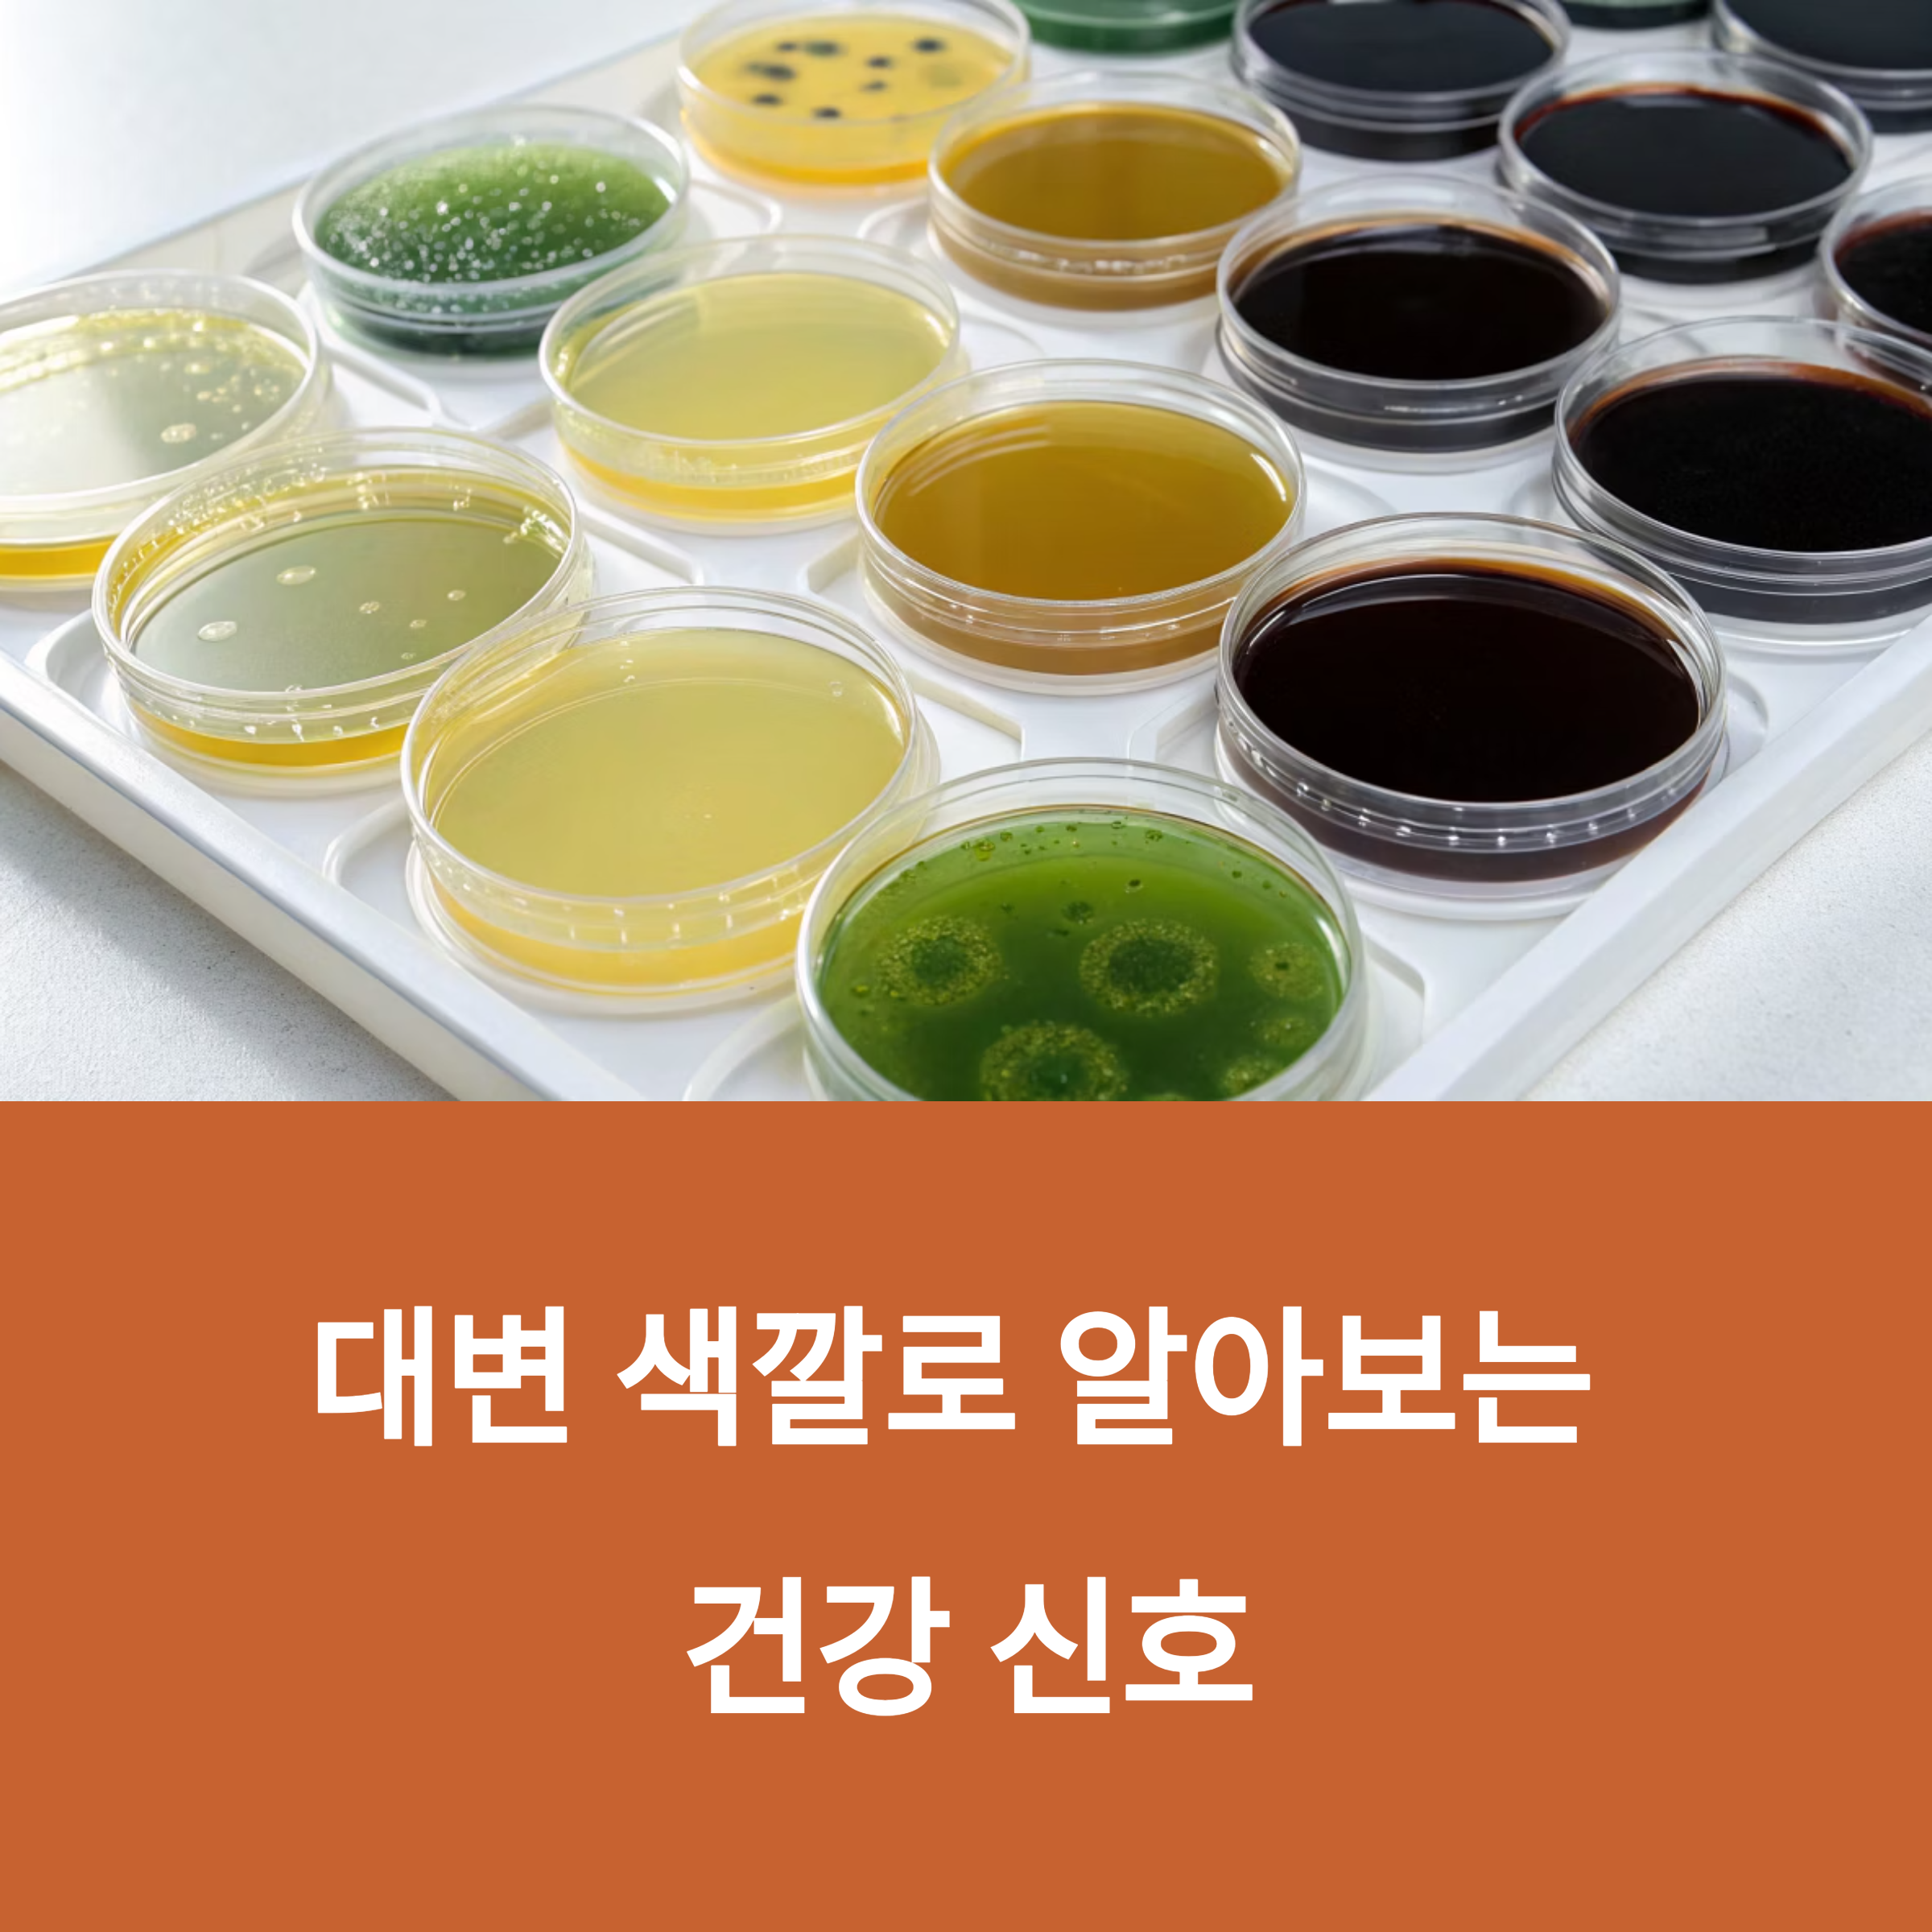

대변의 색상은 간, 췌장, 장 건강을 보여주는 중요한 생체 지표입니다
색깔 변화만으로도 간암, 출혈, 흡수장애 등의 초기 증후를 포착할 수 있습니다
대변 색깔, 단순한 배설물 그 이상일까?
대변은 음식물 찌꺼기뿐 아니라 간에서 배출된 담즙 색소, 혈액, 장내 세균 대사물질의 복합 결과물입니다
따라서 색상이 달라졌다는 건 소화기계 혹은 전신 건강에 변화가 생겼다는 뜻일 수 있습니다
본 글에서는 대변 색깔별로 의미하는 질환, 진단법, 응급 기준을 체계적으로 정리합니다
정상 대변은 왜 황갈색일까?

간에서 분해된 헴(heme)이 빌리루빈으로 전환된 뒤, 장내 세균에 의해 유로빌리노겐으로 변형됩니다
이 유로빌리노겐이 산화되어 **갈색을 띠는 유로빌린(urobilin)**으로 바뀌며 황갈색 대변을 완성합니다
간 기능이 떨어지면 이 경로가 깨지면서 색 변화가 생깁니다
적색 변: 혈변은 어디에서 오는가?
선홍색 대변은 직장 또는 하부 대장의 출혈을 의미합니다
치핵이 흔한 원인이지만, 대장암이나 게실 출혈 가능성도 반드시 배제해야 합니다
특히 40세 이상에서 체중 감소가 동반되면 대장내시경 검사가 필요합니다
흑색 변: 상부 위장 출혈의 경고
흑갈색 대변은 위, 식도, 십이지장 등 상부 위장관에서 출혈이 생긴 경우입니다
혈액이 위산과 만나며 생성된 **헤마틴(검은 색소)**이 대변을 검게 만듭니다
단, 철분제를 복용 중인 경우 가짜 흑색 변이 나타날 수 있으므로 약력 확인이 필수입니다

회백색 또는 점토색 변: 담즙 차단 신호
담즙이 장으로 들어가지 못하면 대변이 회색 혹은 흰색으로 변합니다
주로 췌장암, 담석증, 담도폐쇄, 간경변이 원인입니다
이 경우 피부와 눈이 노래지는 황달이 동반되며, 혈청 빌리루빈 수치도 상승합니다

녹색 변: 장염 또는 급속 장운동
소화가 충분히 진행되지 않은 상태에서 장을 빠르게 통과하면
변에 빌리베르딘 색소가 남아 녹색 변이 됩니다
로타바이러스 감염 아동의 약 40%에서 녹색 변이 관찰되며
3일 이상 지속되면 크론병 등 만성 장질환 감별이 필요합니다

노란 변: 지방 흡수 장애 가능성
노란 대변은 **지방이 소화되지 않고 배출되는 지방변(Steatorrhea)**을 의미합니다
만성 췌장염, 췌장 효소 부족, SIBO(소장 세균 과증식)가 주요 원인입니다
변이 기름지고 물에 뜨며 냄새가 강한 것이 특징입니다
색상 의심 질환 주요 검사

| 적색 | 치핵, 게실염, 대장암 | 대장내시경, FOBT |
| 흑색 | 위염, 식도정맥류 | 상부위장관내시경, CBC |
| 회백색 | 담석증, 췌장암 | 복부초음파, MRCP |
| 녹색 | 장염, 크론병 | 대변 PCR, 복부 CT |
| 노란색 | 췌장질환, SIBO | 엘라스타제-1 검사, 지방변 검사 |
응급으로 봐야 할 대변 신호는?

다음 조건 중 하나라도 해당된다면 즉시 병원 진료가 필요합니다
- 흑색 또는 적색 변 + 어지럼증, 식은땀, 저혈압
- 헤모글로빈 7g/dL 이하 급격한 감소
- AST/ALT 수치가 기준치의 5배 이상 상승
- 회백색 변이 48시간 이상 지속되며 황달 동반
환자에게 알려줘야 할 색상 자가진단법
브리스톨 대변 차트를 활용하여
대변의 색상, 형태, 빈도를 1일 1회 기록하게 하세요
당뇨병 환자처럼 감각 이상이 있는 경우, 출혈 인지가 늦어지므로 더욱 철저한 관찰이 필요합니다
식이 조절로 색상 혼동을 피하자
- 녹색 변: 케일·시금치 하루 200g 이하 섭취
- 흑색 변: 철분제 복용 시 비타민 C 병행 섭취 (흡수율 증가 + 색상 왜곡 최소화)
- 노란 변: 고지방식 피하고 췌장효소제 병행
결론: 색깔 하나로 알 수 있는 건강 경고
대변 색상의 변화는 일시적인 소화 문제일 수도 있지만,
담도폐쇄, 위장 출혈, 췌장 이상, 암 등 심각한 질환의 초기 신호일 가능성도 매우 높습니다
의심 증상이 48시간 이상 지속될 경우
소화기내과, 간담도 전문의, 영양사와 함께 다학제 진료 체계를 가동하는 것이 가장 안전한 대응입니다
